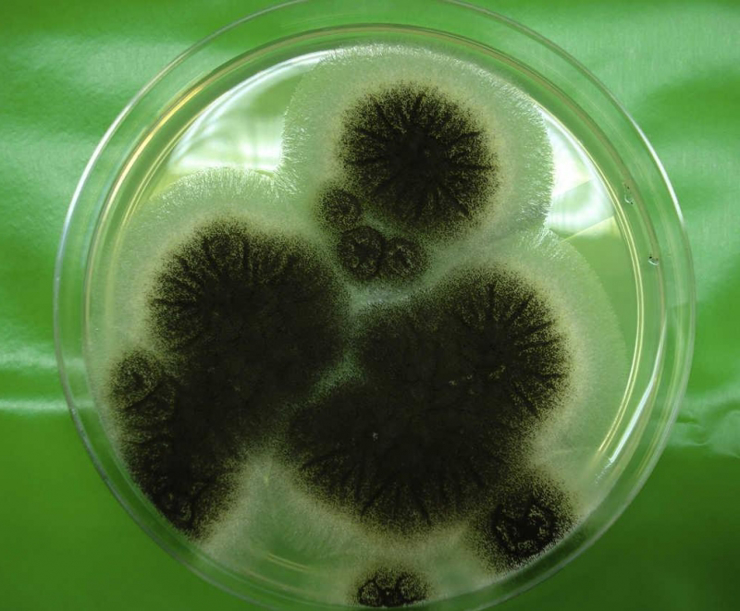

اكتشاف عفن يمنع فيروس كورونا من تطوير نشاطه والتكاثر
توصل مجموعة من العلماء الروس، خلال بحث أجروه إلى أن العفن الفطري الذي ينتمي إلى أسرة “Aspergillus” يتضمن مواد قادرة على منع فيروس كورونا من التكاثر.
وذكرت صحيفة "إزفيستيا" الروسية، أن المادة المذكورة في البحث يمكن أن تشكل أساسا لدواء فعال ضد "كوفيد – 19"، وسيكون أقل سميّة من الأدوية المستخدمة في الوقت الراهن لعلاج المرضى المصابين بـفيروس كورونا.
وفي هذا السياق، صرح مدير مختبر النمذجة الكمبيوترية للأدوية في جامعة جنوب الأورال الروسية الفدرالية، فلاديمير بوتيومكن، بأن فطر Aspergillus قد يسبب في الظروف العادية إصابة الناس بداء فطري قاتل، موضحا “ لكن الدواء الذي أعده العلماء على أساسه لا يهدد الرئتين، إذ أنه عبارة عن مركّب متكوّن من جزيئات بسيطة معزولة من العفن وغير سامة وغير قادرة على التكاثر في جسم الإنسان”.
وحسب، فلاديمير بوتيومكين، فإن فريق العلماء الروس والهنود والبرازيليين جاهزون لإدخال تعديلات في الدواء آخذين بالحسبان البحوث التي أجروها.
وقال الباحث الروسي: “إن الدواء الفطري يمكن أن يحل في المستقبل محل الأدوية المستخدمة الأكثر سميّة بفترة تأثير قصيرة”.
وقام الأخصائيون في جامعة جنوب الأورال الروسية بحساب كثافة المادة اللازمة لمكافحة فيروس كورونا.
ويتوجب عليهم الآن تأكيد تلك المعلومات في ظروف المختبر بالتعاون مع العلماء في جامعة دلهي الهندية.
أما العلماء في جامعة "برنامبوكو" البرازيلية فسيدرسون تأثير الفطر على الحيوانات المصابة بفيروس كورونا.
متابعة نيو ترك بوست